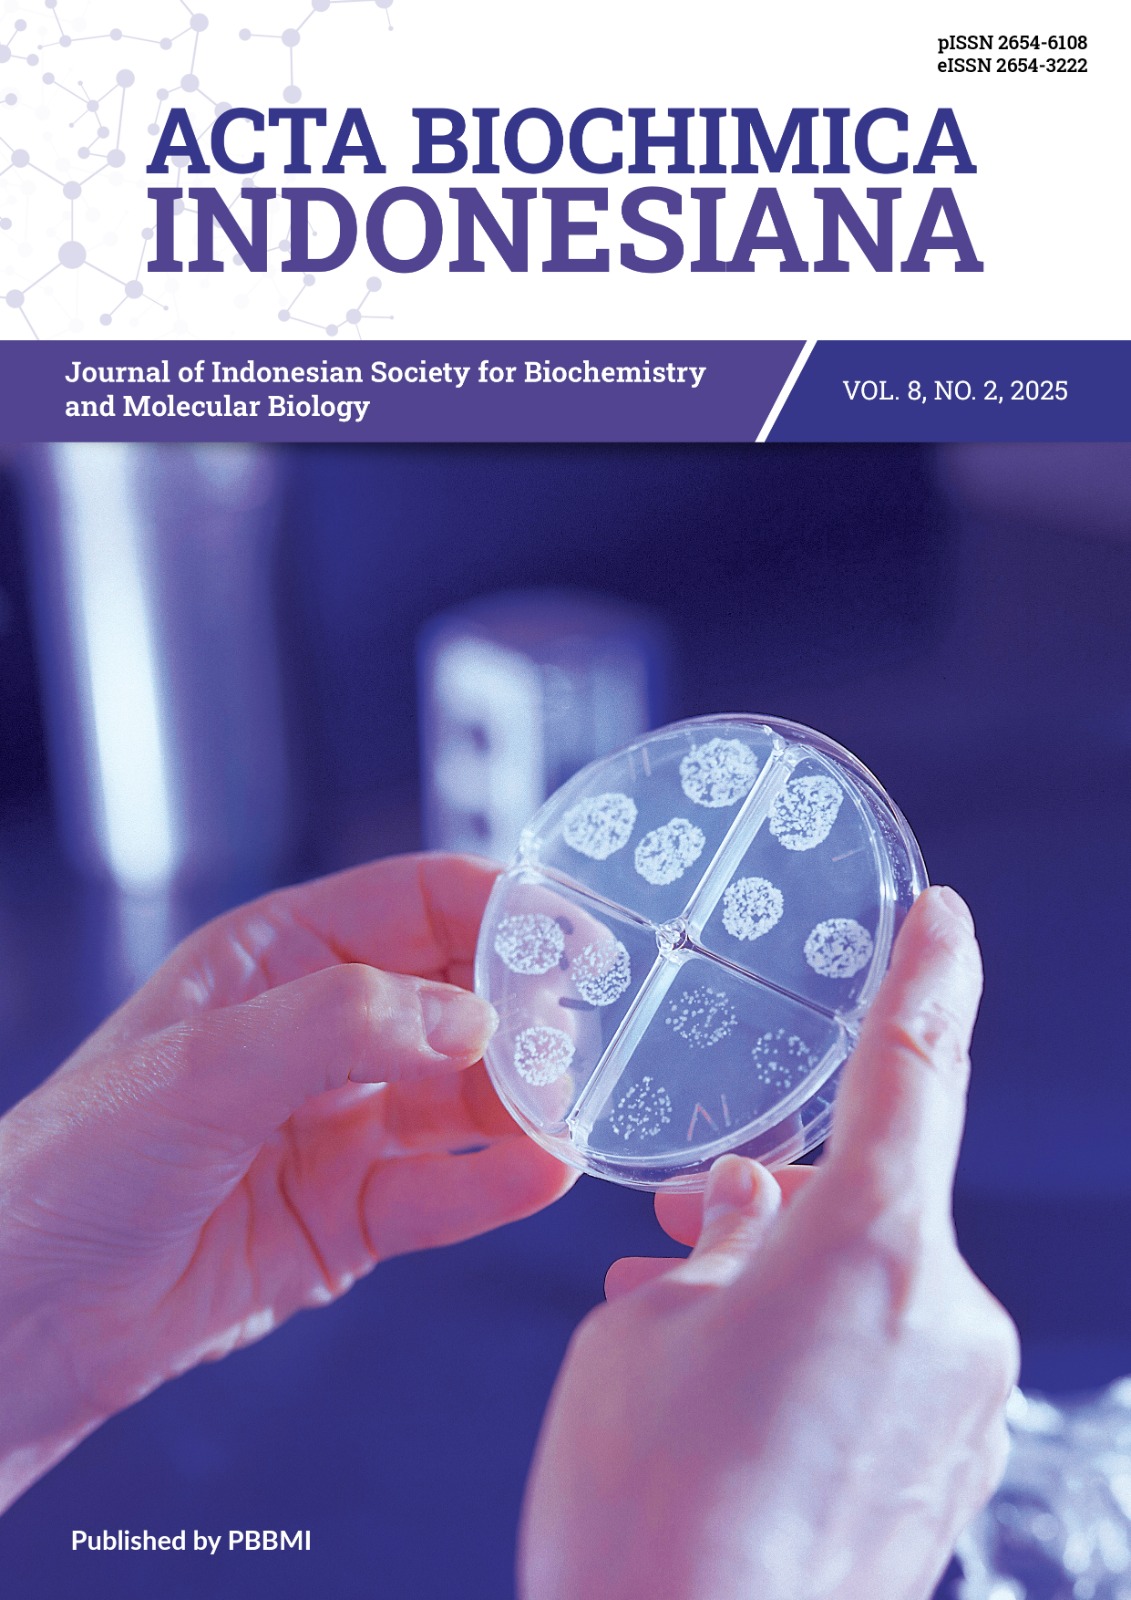

Archives
-
Acta Biochimica Indonesiana
Vol. 8 No. 2 (2025)
Acta Biochimica Indonesiana
Vol. 8 No. 2 (2025)The articles in this issue are contributed by authors affiliated with 10 institutions from 2 countries including Indonesia (Sanata Dharma University, Universitas Syiah Kuala, Jenderal Soedirman University, Nahdlatul Ulama University, Indonesian Red Cross, Universitas Indonesia, Universitas Nusa Cendana, Poltekkes Kemenkes Bandung, Universitas Pendidikan Indonesia) and Philippines (St. Paul University Dumaguete).
-
 Acta Biochimica Indonesiana
Vol. 8 No. 1 (2025)
Acta Biochimica Indonesiana
Vol. 8 No. 1 (2025)The articles in this issue are contributed by authors affiliated with 6 institutions from Indonesia (Universitas Jendral Soedirman, Universitas Islam Negeri Sulthan Syarif Kasim Riau, Universitas Wahid Hasyim, Universitas Nusa Cendana, Universitas Tarumanegara, Institut Teknologi Bandung)
-
 Acta Biochimica Indonesiana
Vol. 7 No. 2 (2024)
Acta Biochimica Indonesiana
Vol. 7 No. 2 (2024)The articles in this issue are contributed by authors affiliated with 7 institutions from Indonesia (Universitas Indonesia, Universitas Brawijaya, Universitas Negeri Malang, Universitas Nusa Cendana, Universitas Warmadewa, Universitas Andalas, and Institut Teknologi Sumatera)
Cover Download -
 Acta Biochimica Indonesiana
Vol. 7 No. 1 (2024)
Acta Biochimica Indonesiana
Vol. 7 No. 1 (2024)The articles in this issue are contributed by authors affiliated with 16 institutions from 3 countries including Indonesia (Universitas Indonesia, Universitas Negeri Jakarta, UPN Veteran Jakarta, Swiss German University, Universitas Sriwijaya, Institut Teknologi Sumatera, Tadulako University, Universitas Nusa Cendana, Prof Dr WZ Yohanes Hospital, Police of the Republic of Indonesia, National Research and Innovation Agency), Malaysia (Universiti Teknologi Malaysia), and USA (Arnold Palmer Hospital).
-
 Acta Biochimica Indonesiana
Vol. 6 No. 2 (2023)
Acta Biochimica Indonesiana
Vol. 6 No. 2 (2023)The articles in this issue are contributed by authors affiliated with 8 institutions from 2 countries, including Indonesia (Universitas Indonesia, Universitas Negeri Padang, Universitas Andalas, Universitas Lampung, Universitas Nusa Cendana, and Bandung Institute of Technology) and India (Integral University and Prasad Institute of Medical Sciences).
-
 Acta Biochimica Indonesiana
Vol. 6 No. 1 (2023)
Acta Biochimica Indonesiana
Vol. 6 No. 1 (2023)The articles in this issue are contributed by authors affiliated with 9 institutions from 2 countries, including Indonesia (Universitas Nusa Cendana, Universitas Gadjah Mada, Lambung Mangkurat University, Brawijaya University, Poltekkes Kementrian Kesehatan Palembang, Universitas Islam Bandung, and Ctech Labs Edwar Technology), and India (Integral University and Jamia Millia Islamia).
-
 Acta Biochimica Indonesiana
Vol. 5 No. 2 (2022)
Acta Biochimica Indonesiana
Vol. 5 No. 2 (2022)The articles in this issue are contributed by authors affiliated with 7 institutions from 2 countries, including Indonesia (Universitas Halu Oleo, IPB University, Universitas Indonesia, Indonesian National Air Force Army, Universitas Andalas) and India (Integral University and Jamia Millia Islamia)
-
 Acta Biochimica Indonesiana
Vol. 5 No. 1 (2022)
Acta Biochimica Indonesiana
Vol. 5 No. 1 (2022)The articles in this issue are contributed by authors affiliated with 10 institutions from 2 countries including Indonesia (Universitas Indonesia, Sultan Ageng Tirtayasa University, Universitas Riau, Universitas Sriwijaya, Universitas Lampung, Swiss German University, RSUD Arifin Achmad Provinsi Riau, and Indonesian Medical Education and Research Institute) and India (Integral University and Jamia Millia Islamia).
-
 Acta Biochimica Indonesiana
Vol. 4 No. 2 (2021)
Acta Biochimica Indonesiana
Vol. 4 No. 2 (2021)The articles in this issue are contributed by authors affiliated with 6 institutions from 2 countries including Indonesia (Universitas Indonesia, Universitas Negeri Jakarta, Universitas Riau, Lambung Mangkurat University, and Dharma Husada Nursing Academy Kediri), and Taiwan (Taipei Medical University).
-
 Acta Biochimica Indonesiana
Vol. 4 No. 1 (2021)
Acta Biochimica Indonesiana
Vol. 4 No. 1 (2021)The articles in this issues are contributed by authors affiliated with 8 institutions from Indonesia (Universitas Brawijaya, Universitas Adiwangsa, Universitas Andalas, Sam Ratulangi University, Duta Wacana Christian University, Universitas Gadjah Mada, Universitas Sriwijaya and Indonesian Halal Certifier LPPOM MUI)
-
 Acta Biochimica Indonesiana
Vol. 3 No. 2 (2020)
Acta Biochimica Indonesiana
Vol. 3 No. 2 (2020)The articles in this issue are contributed by authors affiliated with 9 institutions from Indonesia (IPB University, Swiss German University, Universitas Gadjah Mada, Universitas Muhammadiyah Yogyakarta, Indonesian Health Institute, Indonesian Institute of Sciences, Universitas Jenderal Soedirman, Universitas Riau and Universitas Lampung)
-
 Acta Biochimica Indonesiana
Vol. 3 No. 1 (2020)
Acta Biochimica Indonesiana
Vol. 3 No. 1 (2020)The articles in this issue are contributed by authors affiliated with 5 institutions from Indonesia (Universitas Sumatera Utara, Universitas Indonesia, UPN Veteran Jakarta, Swiss German University, and Universitas Gunadarma)
-
 Acta Biochimica Indonesiana
Vol. 2 No. 2 (2019)
Acta Biochimica Indonesiana
Vol. 2 No. 2 (2019)The articles in this issue are contributed by authors affiliated with 8 institutions from Indonesia (Indonesia International Institute for Life Sciences, Institut Teknologi Bandung, STIFAR Indonesia, STIKes Mitra Keluarga, Universitas Andalas, Universitas Indonesia, Universitas Sriwijaya, and Universitas Tarumanegara)
-
 Acta Biochimica Indonesiana
Vol. 2 No. 1 (2019)
Acta Biochimica Indonesiana
Vol. 2 No. 1 (2019)The articles in this issue are contributed by authors affiliated with 5 institutions from Indonesia (Universitas Lampung, Universitas Indonesia, Universitas Riau, Universitas Sriwijaya, and Universitas Tarumanegara)
-
 Acta Biochimica Indonesiana
Vol. 1 No. 2 (2018)
Acta Biochimica Indonesiana
Vol. 1 No. 2 (2018)The articles in this issue are contributed by authors affiliated with 6 institutions from Indonesia (Lakespra Saryanto TNI AU, Prodia Stem Cell, RS Mohammad Hoesin, Universitas Indonesia, Universitas Sriwijaya, and Universitas Tarumanegara)
-
 Acta Biochimica Indonesiana
Vol. 1 No. 1 (2018)
Acta Biochimica Indonesiana
Vol. 1 No. 1 (2018)The articles in this issue are contributed by authors affiliated with 4 institutions from Indonesia (Universitas Indonesia, Universitas Lampung, Universitas Swiss Jerman, Universitas Tarumanegara)








